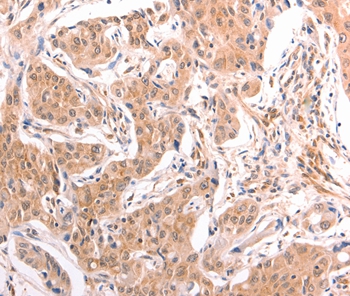
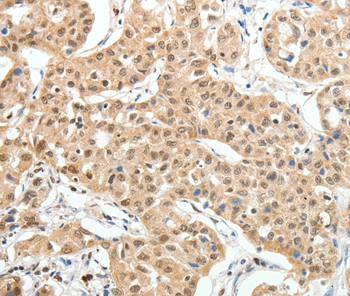

-
分类: 科研抗体货号: P42751别名: AII; AVP; FCU; MWS; FCAS; CIAS1; NALP3; C1orf7; CLR1.1; PYPAF1; AGTAVPRL应用: WB反应种属: Human
-
分类: 科研抗体货号: P42786别名: CIS3; SSI3; ATOD4; Cish3; SSI-3; SOCS-3应用: WB,IHC反应种属: Human,Mouse
-
分类: 科研抗体货号: P42772别名: ILT4; LIR2; CD85D; LIR-2; MIR10; LILRA6; MIR-10应用: IHC反应种属: Human
-
分类: 科研抗体货号: P42784别名: OGC; SLC20A4应用: WB,IHC反应种属: Human
-
分类: 科研抗体货号: P42790别名: SUFUH; SUFUXL; PRO1280应用: WB,IHC反应种属: Human
-
分类: 科研抗体货号: P42771别名: EWI2; PGRL; CD316; EWI-2; KCT-4; CD81P3; LIR-D1应用: IHC反应种属: Human
-
分类: 科研抗体货号: P42783别名: R-PTP-kappa应用: WB,IHC反应种属: Human,Mouse
-
分类: 科研抗体货号: P42789别名: LT; TNFB; TNFSF1应用: IHC反应种属: Human
-
分类: 科研抗体货号: P42798别名: AKAP18;18-kD;AKA7G应用: IHC反应种属: Human
-
分类: 科研抗体货号: P42782别名: HUP1; RMS2; PAX7B应用: IHC反应种属: Human

鄂公网安备42018502007531号
鄂公网安备42018502007531号

